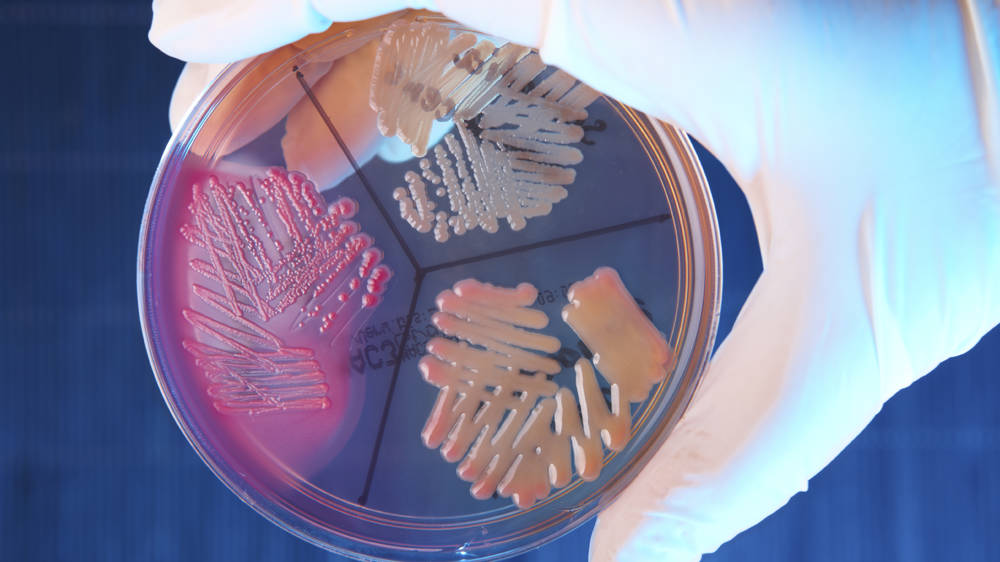
Istock 000012037671Large Istock 000012037671Large

This course includes seven interactive and impactful modules, complete with knowledge checks and exercises to support knowledge retention.
The course is designed specifically as an introduction to the important topic of pharmaceutical microbiology and is intended for those seeking a clearer understanding of the topic.
It reviews the impact of microbiology on many aspects of pharmaceutical manufacture and control. This course looks at the nature of micro-organisms, contamination sources and control, sterilisation and disinfection, and testing methodology (including modern counting and identification techniques).
Before purchasing this module, you can book the free trial version to check that the content and level of the course is right for you.
If you are considering RSSL's eLearning programmes for over 50 participants, tailored package options are available. Contact trainingsales@rssl.com or call +44 (0)118 918 4000 to discuss your requirements.
This course will be of value to all personnel whose roles would benefit from a clearer understanding of this specialist area. This course is ideal for those new to the pharmaceutical industry working in production, technical support, quality control and quality assurance roles. In addition, it will be of benefit to maintenance and support engineers who are involved in production areas and utilities.
This course includes the following topics:

Introduction to microorganisms and how they behave

Ecology and clinical significance

Introduction to sterilisation

Contamination control

Water microbiology

Microbiological testing

GMP in the microbiology laboratory
By the end of the course, delegates will:

Understand the types and sources of different types of micro-organisms that are related to pharmaceutical operations

Be aware of different techniques for the sterilisation of products and the associated components/equipment

Understand what checks and tests can be performed to help manage microbiological issues

As scientists ourselves, we’re passionate about collaboration and sharing our expertise to nurture the next generation. By helping them to develop and fulfil their potential, we can tackle 21st-century pharmaceutical scientific challenges more effectively.

More than 30 years of experience upskilling pharmaceutical professionals

Small-group training adjusted to individual learning styles and needs

50+ training courses accredited by recognised industry bodies

Combination of off-the-shelf and bespoke training packages

Courses and consulting led by experts in the entire pharmaceutical life cycle

Opportunity to share and learn as part of a diverse community